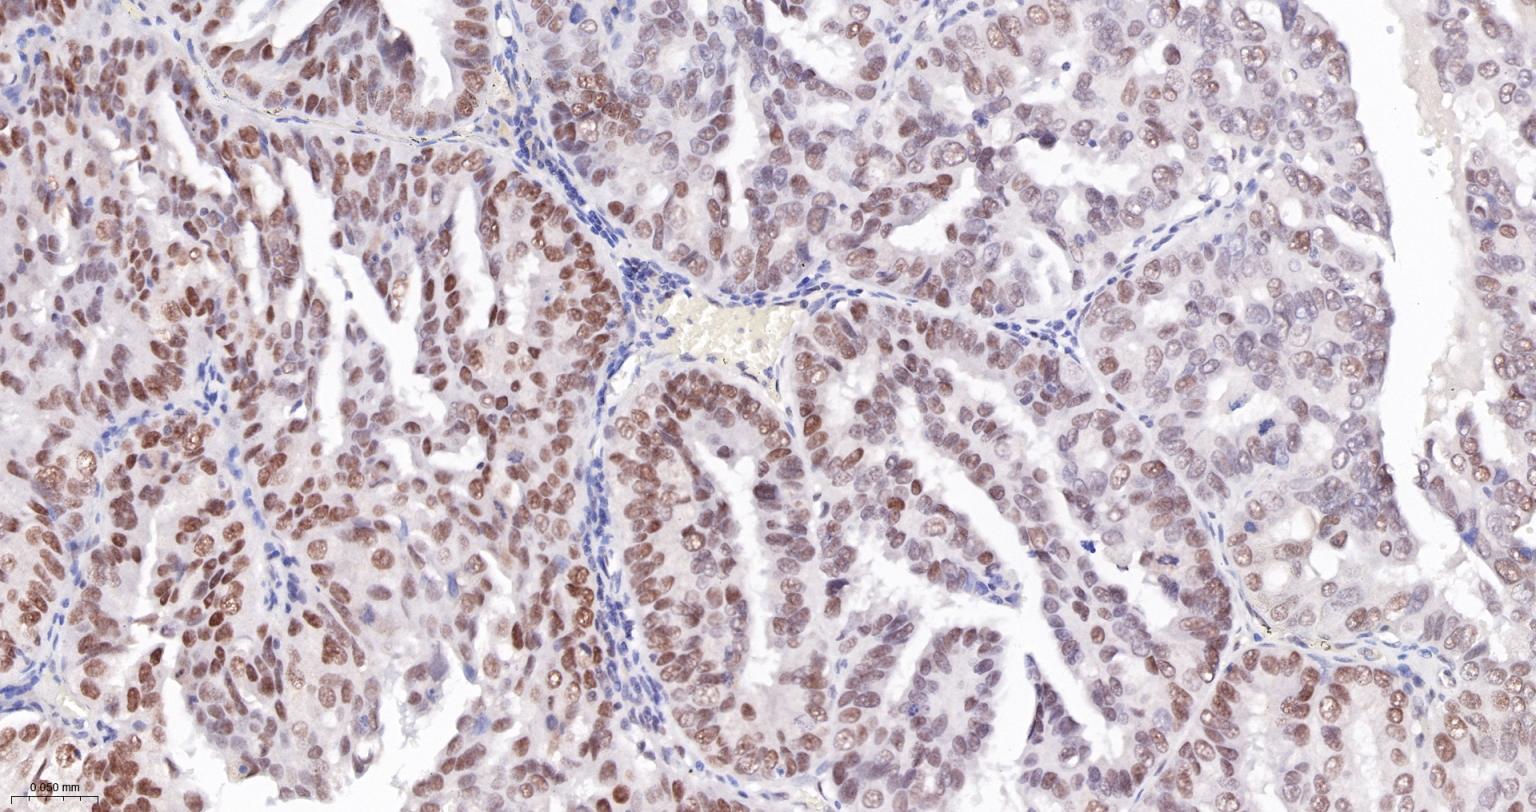
肿瘤错配修复基因PMS2重组兔单抗-bsm-63360R

PMS2 Recombinant Rabbit mAb (一抗) - WB,IHC-P,IHC-F,IF | Bioss
Rrmab?兔单抗

货号:bsm-63360R
产品详情
相关标记
相关产品
相关文献
常见问题
概述
产品编号
bsm-63360R
产品类型
重组兔单抗
英文名称
PMS2 Recombinant Rabbit mAb
中文名称
肿瘤错配修复基因PMS2重组兔单抗
抗体来源
Rabbit
亚型
IgG
性状
Liquid
纯化方法
affinity purified by Protein A
克隆类型
Recombinant
理论分子量
103 kDa
检测分子量
103 kDa
浓度
1mg/ml
储存液
0.01M TBS (pH7.4) with 1% BSA, 0.02% Proclin300 and 50% Glycerol.
SWISS
Gene ID
保存条件
Shipped at 4℃. Store at -20℃ for one year. Avoid repeated freeze/thaw cycles.
注意事项
This product as supplied is intended for research use only, not for use in human, therapeutic or diagnostic applications.
数据库链接
背景资料
This gene is one of the PMS2 gene family members found in clusters on chromosome 7. The product of this gene is involved in DNA mismatch repair. It forms a heterodimer with MLH1 and this complex interacts with other complexes bound to mismatched bases. Mutations in this gene are associated with hereditary nonpolyposis colorectal cancer, Turcot syndrome, and are a cause of supratentorial primitive neuroectodermal tumors. Alternatively spliced transcript variants have been observed for this gene. [provided by RefSeq, Jul 2008].

产品应用
| 应用 | 已检合格种属 | 预测种属 | 推荐稀释比例 |
|---|---|---|---|
| WB | Human | 1:500-2000 | |
| IHC-P | Human | 1:50-200 | |
| IHC-F | Human | 1:50-200 | |
| IF | Human | 1:50-200 |
交叉反应
交叉反应: Human
相关产品
暂无相关产品
靶标
基因名
PMS2
蛋白名
Mismatch repair endonuclease PMS2
亚基
Heterodimer of PMS2 and MLH1 (MutL alpha). Forms a ternary complex with MutS alpha (MSH2-MSH6) or MutS beta (MSH2-MSH3). Part of the BRCA1-associated genome surveillance complex (BASC), which contains BRCA1, MSH2, MSH6, MLH1, ATM, BLM, PMS2 and the RAD50-MRE11-NBS1 protein complex. This association could be a dynamic process changing throughout the cell cycle and within subnuclear domains. Interacts with MTMR15/FAN1.
亚细胞定位
Nucleus.
疾病
Hereditary non-polyposis colorectal cancer 4 (HNPCC4) [MIM:614337]: An autosomal dominant disease associated with marked increase in cancer susceptibility. It is characterized by a familial predisposition to early-onset colorectal carcinoma (CRC) and extra-colonic tumors of the gastrointestinal, urological and female reproductive tracts. HNPCC is reported to be the most common form of inherited colorectal cancer in the Western world. Clinically, HNPCC is often divided into two subgroups. Type I is characterized by hereditary predisposition to colorectal cancer, a young age of onset, and carcinoma observed in the proximal colon. Type II is characterized by increased risk for cancers in certain tissues such as the uterus, ovary, breast, stomach, small intestine, skin, and larynx in addition to the colon. Diagnosis of classical HNPCC is based on the Amsterdam criteria: 3 or more relatives affected by colorectal cancer, one a first degree relative of the other two; 2 or more generation affected; 1 or more colorectal cancers presenting before 50 years of age; exclusion of hereditary polyposis syndromes. The term 'suspected HNPCC' or 'incomplete HNPCC' can be used to describe families who do not or only partially fulfill the Amsterdam criteria, but in whom a genetic basis for colon cancer is strongly suspected. Note=The disease is caused by mutations affecting the gene represented in this entry.
Mismatch repair cancer syndrome (MMRCS) [MIM:276300]: Autosomal dominant disorder characterized by malignant tumors of the brain associated with multiple colorectal adenomas. Skin features include sebaceous cysts, hyperpigmented and cafe au lait spots. Note=The disease is caused by mutations affecting the gene represented in this entry.
Mismatch repair cancer syndrome (MMRCS) [MIM:276300]: Autosomal dominant disorder characterized by malignant tumors of the brain associated with multiple colorectal adenomas. Skin features include sebaceous cysts, hyperpigmented and cafe au lait spots. Note=The disease is caused by mutations affecting the gene represented in this entry.
相似性
Belongs to the DNA mismatch repair MutL/HexB family.
功能
Component of the post-replicative DNA mismatch repair system (MMR). Heterodimerizes with MLH1 to form MutL alpha. DNA repair is initiated by MutS alpha (MSH2-MSH6) or MutS beta (MSH2-MSH6) binding to a dsDNA mismatch, then MutL alpha is recruited to the heteroduplex. Assembly of the MutL-MutS-heteroduplex ternary complex in presence of RFC and PCNA is sufficient to activate endonuclease activity of PMS2. It introduces single-strand breaks near the mismatch and thus generates new entry points for the exonuclease EXO1 to degrade the strand containing the mismatch. DNA methylation would prevent cleavage and therefore assure that only the newly mutated DNA strand is going to be corrected. MulL alpha (MLH1-PMS2) interacts physically with the clamp loader subunits of DNA polymerase III, suggesting that it may play a role to recruit the DNA polymerase III to the site of the MMR. Also implicated in DNA damage signaling, a process which induces cell cycle arrest and can lead to apoptosis in case of major DNA damages.
同靶标产品
相关文献
提示: 发表研究结果有使用 bsm-63360R 时请让我们知道,以便我们可以引用参考文章。作为回馈,资料提供者将获得我们送上的小礼品。